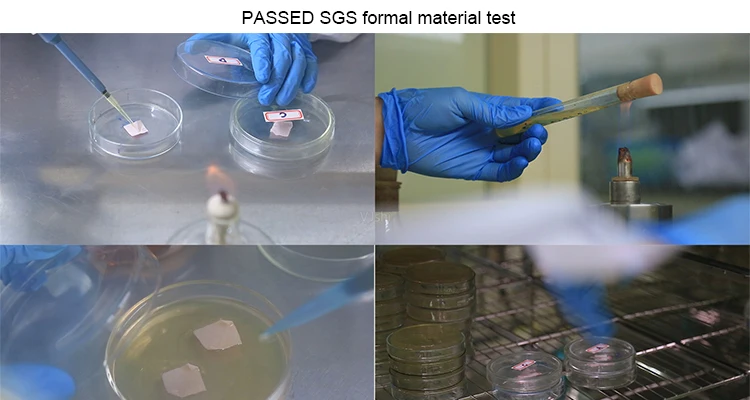

Share on (1600743648554):
Product name | Equestrian Horse Riding wear |
Fabric features: | 1: 87% Nylon + 13% spandex: 305gsm-315gsm 2: 75% Nylon + 25% spandex: 230gsm 3,87% Polyester + 13% spandex, 280-290GSM 4:75% Polyester + 25% spandex, 250GSM |
Size | Multi size optional: XS-XXL. |
Logo | Heat Transfer, Screen Printing,Silicone printing |
Color | More than 40 colors available |
Packing | 1pc/ poly bag, or as your requirements |
MOQ | Custom design 100pcs/color to start, stock product is 20pcs/color |
Delivery time | 25-30days |
Payment terms | T/T, Western Union, , Alibaba Trade Assurance |
Sample | Availalbe |
Delivery time | 7 Days |
Certification | SGS |
Customization | Fully Customizeable |

New products from manufacturers at wholesale prices